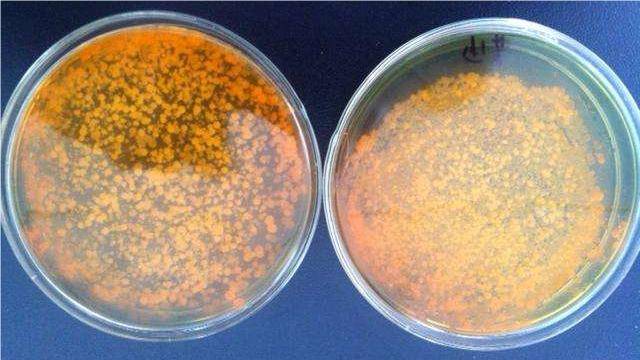
黄弧菌对虾有没有影响?对虾弧菌怎么治疗,建议收藏!_养殖_水体_饲料
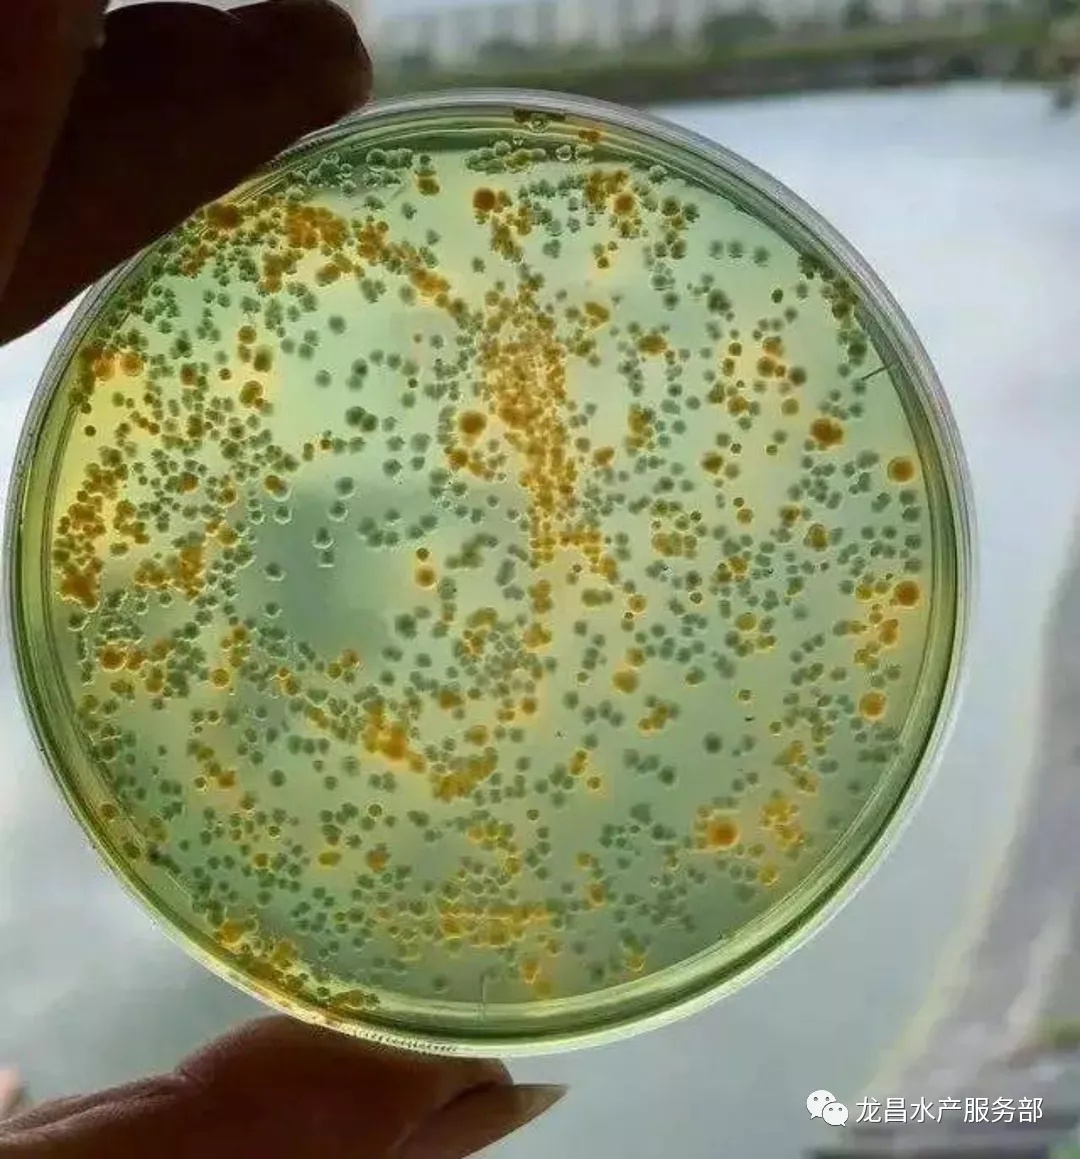
对虾养殖最常见的三种弧菌你知道是什么吗?

黄弧菌

热,持续性低热 2 革兰阴性短小杆菌,革兰染色为沙滩样 弧菌属
图片尺寸455x454
某苗场的玻璃苗检测黄弧菌超标
图片尺寸1080x1119
案例分析: 近段时间弧菌肆虐,从水源到池塘,不论绿弧菌还是黄弧菌
图片尺寸858x511
副溶血性弧菌图片_百度百科
图片尺寸226x170
信息来源泰安大同不凡生物工程有限公司发布时间20206189
图片尺寸900x500
创伤弧菌也可通过伤口感染但黄博士提醒,食源性创伤弧菌感染还有另外
图片尺寸585x364
这几个要点,帮你轻松处理弧菌_养殖_对虾_繁殖
图片尺寸800x528
苗场检测苗体弧菌含量时,弧菌(黄弧菌)含量,小苗不超过30cfu/尾,副
图片尺寸378x473
具有不透明中心和半透明的边缘菌属:革兰氏阴性菌又名:黄弧菌中文名
图片尺寸627x425
想要提高对虾放苗初期的成活率,这四个重点,你知道吗?
图片尺寸500x250
弧菌弧菌属
图片尺寸1200x892
你知道怎么预防弧菌吗?
图片尺寸640x1138
副溶血性弧菌(vibrio parahemolyticus,vp)呈弧状,棒状,卵圆状等多形
图片尺寸1076x1074
黄弧菌对虾有没有影响?对虾弧菌怎么治疗,建议收藏!_养殖_水体_饲料
图片尺寸640x360
创伤弧菌的典型形态和关键特性
图片尺寸823x534
视频教学弧菌检测及灭弧实验
图片尺寸478x512
关于池塘最适碳氮比和弧菌的关系
图片尺寸586x596![弧菌的克星.[爱心] 养殖朋友发来的图片 用弧号前后的对比 - 抖音](https://imgs.wantubizhi.com/img/735A5D1F980B52A636CC46F12F2D1A7362405A7634BD94A89BC5FA18DD0A1537A8C8700173450EA33A67C833F4B1FA7E092062B90A319DD19A5BC8964E77A94A599F1E6D55CDC69BE1ECEECFA715DB0280B6C096716DEAD3B7240AF639B418E1)
弧菌的克星.[爱心] 养殖朋友发来的图片 用弧号前后的对比 - 抖音
图片尺寸1080x1440
泰州市生物杀毒消毒剂产品咨询弧菌
图片尺寸370x800
对虾养殖最常见的三种弧菌你知道是什么吗?
图片尺寸1080x1159
















![弧菌的克星.[爱心] 养殖朋友发来的图片 用弧号前后的对比 - 抖音](https://imgs.wantubizhi.com/img/735A5D1F980B52A636CC46F12F2D1A7362405A7634BD94A89BC5FA18DD0A1537A8C8700173450EA33A67C833F4B1FA7E092062B90A319DD19A5BC8964E77A94A599F1E6D55CDC69BE1ECEECFA715DB0280B6C096716DEAD3B7240AF639B418E1)




.jpg)

![弧菌的克星.[爱心] 养殖朋友发来的图片 用弧号前后的对比 - 抖音](https://p3-pc-sign.douyinpic.com/tos-cn-i-0813c001/dadc719248c34a2a870e5f8c4369d071~tplv-dy-aweme-images:q75.webp?biz_tag=aweme_images&from=3213915784&s=PackSourceEnum_AWEME_DETAIL&sc=image&se=false&x-expires=1696917600&x-signature=hCc /DLgb1Hc0u0lUED5MXzMMjI=)